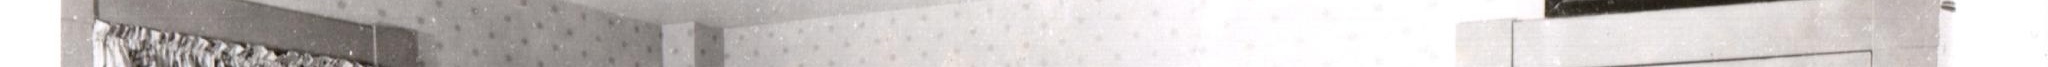

Photograph
Photograph

| Photograph: | 10567-427 |
| Group: | 10567 |
| Image Number: | 427 |
| Disposition: | VA Collections |
| Image Status: | Acquired |
| Location: | Unknown |
| Image Type: | Postcard |
| Event: | Interior |
| Num Persons: | Unknown |
| Part of Album: | No |
| URL: | https://www.visualancestor.com/image/?group=10567&image=10567-427 |
| Date (Est): | 1900-1935 |
| Determination: | Deduction |
 |
|
| Front Inscription: | auto detected: and ... HOME |
| Back Inscription: | None |
| Other Inscription: | None |
| Provenance: | None |
 |
|
| Active: | True |
| Access: | Group |
| Created: | March 11, 2026 |
| Contributor: | CuratorInChief |
| Curator: | CuratorInChief |
| Archivist: | CuratorInChief |
b4cd3a05-5e1c-4f91-a1a9-274bba1d32c3
 Photographer
Photographer

| Photographer: | 99999 |
| Individual Name: | Unknown |
| Business Name: | Unknown |
| Determination: | Unknown |
| Num Locations: | 1 |
| Location Number: | 1 |
| Determination: | Unknown |
| Loc Begin Date: | Unknown |
| Determination: | Unknown |
| Loc End Date: | Unknown |
| Determination: | Unknown |
| Address: | Unknown |
| City: | Unknown |
| State: | UN |
| Country: | Unknown |
| Note: | 99999 is used for the unknown catch-all |
| Active: | True |
| Archivist: | CuratorInChief |
8127bfc8-20e0-4aa2-a318-2f39423991fd

 Comments
Comments

No comments found for this item.

 License and Citation
License and Citation

| License: | Public Domain Standard: Visual Ancestor provides access to this and other related digital works based upon evidence that they exist within the Public Domain with no rights restrictions upon them, nor any other restriction on their use. We hold this belief based upon the age and nature of these works, and lack of evidence of any copyrights in effect. However, we do not provide any guarantee, implied or actual, that this is necessarily the case and advise you to arrive at your own conclusion before using these works. If you have evidence that these works are protected by a legally valid copyright, please report such evidence to us for immediate action. Submit take-down request. More about licensing. |
| Citation: | Photograph 10567-427. https://www.visualancestor.com/image/?group=10567&image=10567-427. In the digital collection No Name. Visual Ancestor Library of Photographs from 1840-1940. June 14, 2026. |

 Facial Recognition
Facial Recognition

Facial Recognition is an advanced feature of Visual Ancestor whereby each face within this photograph (up to a maximum of ten) is compared to all other faces in the Visual Ancestor Library. Faces that are similar above a 92.00% similarity threshold are presented. The higher the similarity, the more likely the faces are of the same person.
|
|
Click to hide (or show) video content...
|
Using Facial Recognition
In this video, we cover how to use Facial Recognition to possibly find ancestors in other photographs after you have archived photographs into the Visual Ancestor library.
!! Videos on YouTube only work when "Allow All" cookies is chosen. To honor your choice, we have disabled this feature. !!
You may visit the Terms of Service page to change your cookie preference.
You may visit the Terms of Service page to change your cookie preference.
|
|
Click to hide (or show) transcript of video...
|
Hello and welcome to Visual Ancestor. I am the chief curator and in this instruction video I'd like to talk about facial recognition. So many of you have heard about facial recognition, probably seen it in action. So for those of you who might be unfamiliar with it, facial recognition is a um aspect of machine learning which is a subset or subcategory of AI, artificial intelligence. that can identify and compare faces in photographs and sometimes in video against faces in a database and it can um link faces together. It can return results. Yes, this person is here. No, this person is not here and some sort of degree of certainty. So that's facial recognition. And in visual ancestor, we do use facial recognition to attempt to identify ancestors in photographs. Where to find it? So where where do I go to actually see facial recognition? Well, you would go to a photo view. So you would log in because it is only available to members. And you would navigate to a particular photo. Here on my screen, I am showing the group profile for group 10259. It's a public group, so you can also um go to that group and look at it yourself. And I'm just going to scroll down to the list of thumbnails of images in this group. I'm just going to click on the very first one. Here is the photo view of this photo graph, front and back. And as I scroll down, I have the various sections of the photograph view. And if I scroll all the way down to the section entitled facial recognition, this is where you would see the results. Um, it seems as though I've actually chosen a poor photo to illustrate because here in this black box down here under face one, it says that there are no matches. So that's actually a bad example. Let's try the second image here. So, bring it up. Scroll down to the uh facial recognition section. There will be this video that I'm recording right now um embedded in here, which you don't see yet, but uh in this section, you will see the beginning of the major section where you have the results and it says faces in photograph 10259-102. All right. So, what are the parts here in the results? Well, first of all, facial recognition compares faces. So, you kind of get that feel as you look at um a section entitled top matches and you see an array of photographs and a percent similarity above it and the photograph number uh below the thumbnail. So you kind of get the impression right away that what this is doing is it is comparing the face in this photograph, this main photograph we're viewing against the entire database and it's returning back to us all possible matches. I stress the word possible that have come back with a similarity rating at or above 92%. And it gives you it ranked in order from high. So you see 97.8% up here all the way down to the low 92%. If I go back to the top now that we kind of get a sense of what this is, let's look at the parts. So first we have some statistics about the photograph itself. So up here it says faces found. Yes. number of faces one because we are starting with this photograph that we're in full view of. Then it says minimum similarity 92%. That's because we have to set a minimum similarity threshold above which we are returned possible matches. Maximum number of faces 20. What that means is the maximum number of faces in a photograph we can execute comparison against is 20. If there are more than 20 people in the photograph we're viewing, um facial recognition just will will not execute. Okay. If there are multiple faces in the photograph, we're going to have multiple uh of these sections where we are presented with returned results. So we only have one face in our photograph. So therefore we only have one section of return results entitled face one. So we see down here now we're looking at the face. We're not looking at the photograph but now the faces in the photograph as we look at sections like these. So we're giving the face ID right here. This long string string of numbers uniquely identifies the face imprint of this face here in the main photograph we're viewing. What I mean by the face imprint is the facial recognition kind of describes this face in the database and it gives a unique identifier to that entry in the database. confidence 100%. All that means is that the facial recognition procedure is extremely confident that it is able to see clearly this woman's face and identify all the markers of her face that it needs to fully um flesh out the facial recognition profile for her face. Age range and infer gender is more of a new feature that we kind of put in here. So, we don't have it running on all of the photographs, but we do on the um the more recently um archive photos, but I have seen where these are very wrong. So, I would not put a lot of stock in the um age range that it guesses and also the gender that it guesses. Number of matched faces. That means that when um it takes this face profile described by this unique identifier which is again this person's face and it does the facial compare procedure on all the faces in the entire database. It comes back with 12 possible matches that are equal to or greater than the minimum similarity of 92%. And those 12 faces are presented to us here in this black area. Remember again, if the photograph that we're viewing has multiple faces, there will be multiple of these sections. Right now, we just have one because there's just one face. So what this is saying in a nutshell is this woman's face when facial recognition compares its profile described by this unique identifier against all the faces in the database. It comes back with these 12 possible matches starting with the highest percent similarity, which is this woman's face in this photograph 10173-425 with a 97.68% similarity. And on down as we decrease the percent similarity all the way down to uh this one here at 92.02%. 02%. Okay, there you just really have to get a good feel for possible matches and the percent similarity. Um, I can tell you just by my experience that 92% is absolutely nothing. It's like no basis of even coming close to identifying the same people in different photographs. I've seen uh photographs that I know are of the same person that have a similarity comparison of like 96%. So once we start getting upwards from 92 to 93 into the 96s, that's when in my experience I've seen cases where I know the people are the same but 96 is you know kind of lowish on the scale. you really want to really put the focus on um the percent similarities that are like 97 and above 97% and above especially the 99s. Okay. So that is explaining to you the parts of how the facial recognition results are returned to you here on this web page when you browse a photograph. So now instead of the actual parts of this section of facial recognition, let's look at um how to get it working with your photos. How do I actually use facial recognition? Well, facial recognition is an automatic scan that happens when you upload a photograph. specifically the front scan which would be side A of your photograph when you are archiving your photographs. So we did some videos on that but just as a very quick review if I go here to the top right I drop the pancake menu down um and I choose uh groups which I'll open up in a new tab. Um, I'm going to click on a group that I've created just for illustration purposes. And we have uploaded this photograph as an illustration when I made the instruction videos of the fourstep process of how to archive photograph. So, if I click on that photograph, I get the photo view. And if I scroll to the bottom, I do have some results in the facial recognition section. But how I got these results to appear is automatically when I went ahead and uploaded this photograph. I'm not going to upload a new photograph, but if I click on the edit photograph button to bring me back into the four-step process, 1 2 3 4. If you remember, we uploaded this photograph by dragging and dropping the JPEG file into this boxed area. As soon as I do that for scan A, which remember is always the front of the photograph, when I drag and drop and it uploads it into the database and data storage, it is automatically as a part of that process going to enter the facial recognition into the the database. So that's how you get facial recognition working for the photographs you upload. It's automatic. It happens behind the scenes as soon as you drag and drop your front scan into this area here for scan A. When you view the photograph in the photo view, you can then scroll down to the facial recognition section and see the results. It will either say no results returned or you'll see the listing out of the faces that facial recognition found in your photograph and the top matches. Okay, let's take a closer look at facial recognition. We've already went over what the percent similarity is, so I don't feel like I need to repeat all of that. So, let me move on to the second point looking at facial recognition a little closer. And the thing that I want to stress is you should approach it as a tool of many tools that you use to forensically work with photographs, trying to identify people, trying to find more ancestor photographs. It's one of many tools. It's not the only tool, especially if you get an insinuated match that you think is a match because the percent similarity might be really high. It's not something to completely rely on. You have to look at other factors and use other tools. So, you want to look at where where the potential matched photograph is from, who the photographer is. Does the location fit the story of your ancestor. Of course, there are always deviations like, well, you know, your ancestor could have visited a relative 200 miles away and he got his photograph taken there, but that's probably the rare exception, not the norm. So you want to look at corroborating evidence. All right. So facial recognition says that these two photographs are a potential match. The percent similarity is really high, 99%. Does the location, if it exists on the photograph, does it make sense? Is there corroborating evidence there? When you actually look at the faces side by side, what does your judgment tell you? Secondly, are the people identified? And if they are, do they have the same names? So you want you want to corroborate the results that facial recognition returns. Let me show you an example as my third point where facial recognition works exceptionally well and that is with um let's see here that is with the group that this photo is from. So let me go to group 10259 which is a public group. You can pull it up on visual ancestor yourself. And the really cool thing about this group is this group is comprised of a photo album. And we can see the front cover of the photo album here. Uh where it tells us that there is a group album. As I scroll down a little bit, I get all of the thumbnail views of the photographs in this group. And because it's an album, these are also the photographs in the album. Um let's look at the album. So I'm going to click on the album. And we're in the album view. So, we get the covers, we get the spine, and if I scroll down, I get that annoying popup again. Sorry about that. Here are all the album pages. So, we get the sense that this is a family album. A lot of these people must be somehow related. There must be duplicate photos of the same individuals among all of these photos here. So I am going to focus on this particular photograph in that album, photograph 117. So here's an individual from that photo album. If I go down to where he would be named if he were identified, which is right above the photographer section, we see that there is no name. So it's an unidentified individual. And as we scroll down to the facial recognition section, I want to show you all of the matches here because look at the percent similarity that is being returned back to us. 100%. 100% 99.99% 99.58% and so on. The first picture here looks identical to the image we're viewing, but the image we're viewing is image number 117. And the first photo being returned back to us from the facial recognition comparison is image 141. So this is not the same physical photograph, but this is a duplicate. So remember uh from your history photographic history person went to the photographer um after the negative was fully viable. So from about 1865 onward he would have a sitting he would have his photograph taken and basically for a dollar or two he would get a dozen of the physical photographs of the same sitting to hand out to relatives and friends etc. So in this particular group of photographs in this album, there is actually two out of maybe a dozen photographs that this individual was given from this sitting. And that's why the similarity is 100%. All right, let's look at the second one. The second photograph is a different photograph, but it's still coming back at 100% similarity. Now, here's where looking for corroborating evidence is really important. What I'm looking for is is this photograph from the same group? Because when we preserve groups of photographs, that's metadata that we're preserving. Because photographs that are bundled together in the same group or box or lot or collection, whatever word you want to use, can sometimes be related. And so that is a piece of corroborating evidence. And indeed, if we look at the photograph number, remember the photograph number begins with the group number, we see that this photograph is also from group 10259. So, we have a second piece of corroborating evidence that this is the same individual, but it's not enough because it could be a brother, it could be a twin. So still, you know, we're we're really high on our threshold for saying that this is the same individual, but we still have to keep that level of healthy uncertainty about it. It could be the same individual. But one thing we can do is rightclick and we can open that photograph in a new window and we can scroll up and kind of like do our own comparison looking at like the lip shape, the eyebrows are identical. I mean, come on. The ear shape, how how curvy it is. It almost looks the mirror image of this one. Um the fact that facial recognition says that this is 100% means that the formation uh of the facial features and their relative positions to one another are are identical and so I would be comfortable in presenting this as the same individual. Okay, let me close that and let me scroll down. We have another photograph that is 99.99% similar. Okay. And it's from the same group. We see 10259. Same group. Um, image 106. And let's open this up in a new view. And let's do a visual comparison. And I can see immediately immediately that this individual is the guy in the middle. So again, we're looking for corroborating evidence, not just relying on the 99.99%. And when when you see this, you can pick them out immediately. They're this they're again, that healthy degree of uncertainty is is holding me back from saying that these are the same persons, but I have a story to tell. I can say, you know, it is kind of beyond a reasonable doubt that they are. Can't be 100% certain, but beyond a reasonable doubt. Let's look at another um piece of corroborating evidence and that's location. If I look at the back of this photograph here, I can see that this photo was taken to Pika, Kansas. If I go back to the originating photograph that we're really scrutinizing and looking at, this is also from Topeka, Kansas. So, we are building a story where the preponderance of evidence is saying that these are the same individuals. Okay, so let me close that out. This is a case where facial recognition works extremely well. Let me show you another case of where facial recognition worked very well to identify an unknown Civil War soldier. So, I have a photograph that is from the Library of Congress from the Lao Jenkoist family civil war collection. Um 5013162. I'm going to pull this up for us. Uh let me go to search. Submit the search. Here's the photographs returned and I'll click on it. Okay. So, here we have a a photograph of a sailor from the La Jenquist Civil War collection held at the Library of Congress. I know that because of the source information below as well as the citation if I were to read um the citation. Okay. So when I go down to the facial recognition section of this guy, I actually find this photograph 98.56% similar from group 1073. So let me open this up in a new view and let me scroll up and let me just click on the front view just to expand this out. The point that I want to make is I can't say for certain they're the same people because we always have to have a healthy academic approach or a scientific approach to facial recognition. Um, however, facial recognition was able to match this Civil War soldier to another photograph in in our collections, this individual. What's the other piece of corroborating evidence? Well, there isn't much here because the person in this Civil War uh photograph is unidentified. I can't link the names up. But what I can say is, you know, to the best of my ability, when I look at the face and I compare the face in my mind, the facial features of this individual are so uniquely striking. his eyes, the way they're close together and and kind of high on his head, his long nose, the the lips, the shape of his lips. When I look at that, I am convinced personally that this is either the same individual or a guy that is substantially similar in appearance. Again, can't say for certain that they are, but the point is this is an example of how facial recognition may have identified this unknown Civil War sailor. All of this gives us a totally new area that we can tell a story about. We can build a case now using another tool called facial recognition. And we can write about it in our genealogy, in our family history. But here's the word of caution. You can have false positives. So that's why we have to be careful. A false positive would be a result that is returned. I'm going to go back and look at the full photograph view. Um, a false positive would be a result that is returned like this photograph here. 98.56% similar that actually is not the same individual. and we can kind of know it. That's a false positive. So, let me show you an example of a false positive and then we'll conclude. So, I have another uh photograph I'm going to pull up. I'm just going to very quickly use the search feature to find it. It's 5001-5976. And we have a Civil War soldier. And I'm going to scroll down. Okay. So, this set of results here is giving me a photograph that has an extremely high percent similarity. 99.94. Wow, that is high. But I'm going to rightclick. I'm going to open up in a new view. I'm going to put them side by side. So, I ordinarily might be convinced if someone showed this to me, especially if they're making an argument that they're the same person. Um, I might be suspect because the noses are different. Um, this guy's nose I can immediately recognize is different from that guy's nose. But just superficially, 99 something% is really darn close. But if I scroll down, uh, this guy is identified as Henry Harrison Ael. This Civil War soldier is also identified as um, Ozro J. And since those identifications come from first person accounts um just because of the nature of this particular collection of photographs that is evidence that they are not the same person definitively not the same person. So this would be a false positive and this is why you have to be careful with facial recognition. Okay. In conclusion, facial recognition is pretty exciting and there's a we definitely have enough content to be useful, but you have to use it carefully. Use solid science, solid argumentation. Look for corroborating evidences and always hold yourself back from saying definitively this is the same person. But that's okay. Even if you inside, you know, don't really want to say that they are, you still have another tool in your tool belt to write about it, to make an argument and to communicate that to descendants, preserving your research, preserving your findings and again making that um argumentation. So, thank you very much for bearing with this long extended video. I am not the very best explainer, but I I did my best here. Um, let me know what you think and happy hunting. Thank you very much.
Facial Recognition is only available for members of the Visual Ancestor Library. Membership is free -- join today.

 Notes
Notes

Notes about Altering Photographs
It should always be the case to present the original, unaltered photograph as it really exists as the true obverse "a" side, and likewise the original, unaltered back side as the true reverse "b" side. This ensures the true nature and appearence of the photograph is preserved in an original and unaltered state. If the photograph warrants repair, enhancement, or restoration, this would make for excellent "additional sides" to include along with the original "a" and "b" sides. This is why some photographs have these additional "c" and sometimes "d" sides.
Notes about Photograph Quality
For best preservation, photographs should be scanned at a minimum resolution of 600 dpi (dots-per-inch) for the obverse side, and a minimum of 300 dpi for the reverse side. It is better to capture too much quality and image detail than too little. Tiny photographs can be scanned at 1,200 dpi. Scanners usually have settings that allow you to adjust scanning resolution.
Image compression also plays a factor in image quality. Higher compression means image quality is lower, but the file size commensurately decreases. File formats that are "lossless" have no compression (thus maximum quality), but may consume more memory space than what is really needed. Visual Ancestor uses JPG images with 5% compression (95% quality factor) for the obverse side, and 10% compression (90% quality factor) for the reverse side.
Notes about Shading and Hues
The shading and hues of color of a photograph can vary from when it appears in an album page (usually lighter and dominated by lighter hues) to when it is scanned alone (usually darker and dominated by darker hues). This is due to how a scanner or camera adjusts the overall shading and coloring of the overall image based upon the entire field of light that it captures.
The surface area of album pages, which are usually very light in shading, influences how the photographs appear therein. This is why a photograph in an album page may appear lighter and dominated by lighter hues, while the exact same photograph when viewed alone may appear darker and dominated by darker hues.
It should always be the case to present the original, unaltered photograph as it really exists as the true obverse "a" side, and likewise the original, unaltered back side as the true reverse "b" side. This ensures the true nature and appearence of the photograph is preserved in an original and unaltered state. If the photograph warrants repair, enhancement, or restoration, this would make for excellent "additional sides" to include along with the original "a" and "b" sides. This is why some photographs have these additional "c" and sometimes "d" sides.
Notes about Photograph Quality
For best preservation, photographs should be scanned at a minimum resolution of 600 dpi (dots-per-inch) for the obverse side, and a minimum of 300 dpi for the reverse side. It is better to capture too much quality and image detail than too little. Tiny photographs can be scanned at 1,200 dpi. Scanners usually have settings that allow you to adjust scanning resolution.
Image compression also plays a factor in image quality. Higher compression means image quality is lower, but the file size commensurately decreases. File formats that are "lossless" have no compression (thus maximum quality), but may consume more memory space than what is really needed. Visual Ancestor uses JPG images with 5% compression (95% quality factor) for the obverse side, and 10% compression (90% quality factor) for the reverse side.
Notes about Shading and Hues
The shading and hues of color of a photograph can vary from when it appears in an album page (usually lighter and dominated by lighter hues) to when it is scanned alone (usually darker and dominated by darker hues). This is due to how a scanner or camera adjusts the overall shading and coloring of the overall image based upon the entire field of light that it captures.
The surface area of album pages, which are usually very light in shading, influences how the photographs appear therein. This is why a photograph in an album page may appear lighter and dominated by lighter hues, while the exact same photograph when viewed alone may appear darker and dominated by darker hues.
Visual Ancestor's Cookie Policy
Visual Ancestor uses cookies to make our website work and to learn about you in a non-intrusive way. We also use third-party services like Google Analytics, YouTube, and PayPal. Our carefully chosen cookies allow us to give you the best possible experience.
We honor your privacy and right to choose among the following preferences. Learn more by reading our Cookie Policy within our Terms of Service (defaults to essential only). Clicking the "x" to close this notice also accepts all.
We honor your privacy and right to choose among the following preferences. Learn more by reading our Cookie Policy within our Terms of Service (defaults to essential only). Clicking the "x" to close this notice also accepts all.